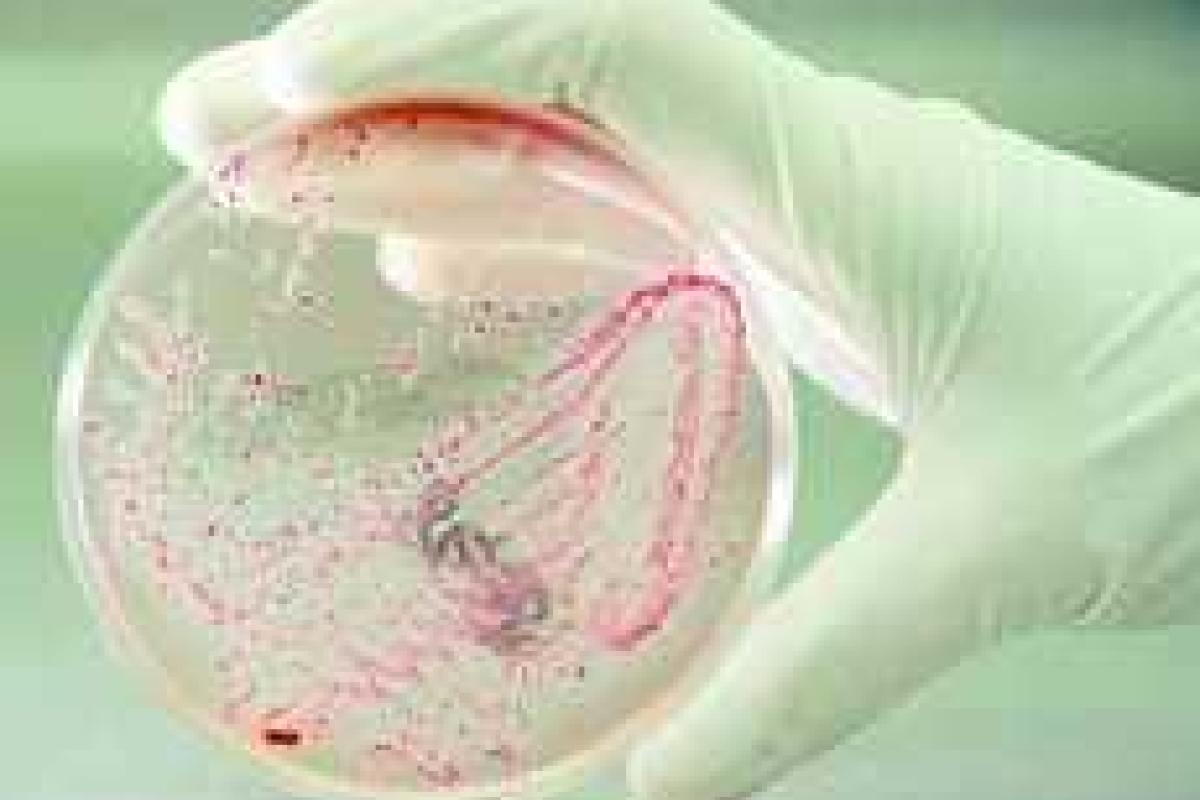
К 2050 году бактерии станут опаснее рака К 2050 году бактерии станут опаснее рака

Наиболее безжалостными убийцами на Земле являются бактерии – они могут лишать жизни до десяти миллионов человек ежегодно. Этот неутешительный вывод сделали британские эксперты. Они сказали, что если человечество в ближайшее время не найдет способа противостоять бактериям, выработавшим устойчивость к антибиотикам, то к 2050-му году каждый год будет умирать по сто миллионов человек. Это значительно больше, чем от рака (согласно данным ВОЗ, Всемирной организации здравоохранения, от онкологических заболеваний в мире ежегодно умирает примерно по 8 миллионов человек). Сейчас от устойчивых к антибиотикам бактерий гибнет по семьсот тысяч человек в год.
Компьютерная модель продемонстрировала, что в ближайшие годы сопротивляемость к антибиотикам бактерий, провоцирующих развитие туберкулеза, малярии, кишечной палочки увеличится. Параллельно с этим ученые подсчитали, какое количество средств потребуется, чтобы спасти человечество от этой угрозы. И назвали цифру в сто триллионов долларов.
В Австралии, Австрии, Канаде, Франции, Японии, Норвегии, Словении, ЮАР, Швеции и Великобритании доказаны многочисленные случаи устойчивости к лечению от гонореи – заболевания, которым каждый день во всем мире заражается более 1 миллиона человек.
Первое широкое исследование ВОЗ о резистентности к антибиотикам отмечается на семи бактериях, отвечающих за подобные распространенные и тяжелые заболевания как сепсис, диарея, пневмония, инфекции мочевых путей и гонорея.
Напомним, в 2010 году глава Министерства по делам семьи, молодежи и спорта Равиль Сафиуллин сообщил, что к 2050 году население Украины может сократиться до 25 миллионов человек.
Также, согласно данным министерства, население Украины за 15 лет уменьшилось с 52 миллионов человек до 46 миллионов человек.
















